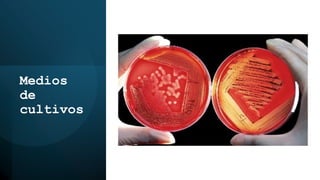
Medios
de
cultivos
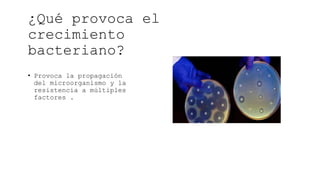
¿Qué provoca el
crecimiento
bacteriano?
• Provoca la propagación
del microorganismo y la
resistencia a múltiples
factores .

El ciclo celular es el proceso mediante el cual las células se dividen y reproducen, incluyendo fases críticas como G1, S, G2 y M, donde ocurre la replicación del ADN y la mitosis. En organismos unicelulares, la división celular se realiza por fisión binaria, mientras que en eucariotas se lleva a cabo mediante mitosis y meiosis. La comprensión del ciclo celular es fundamental para el crecimiento microbiano, la reproducción celular y el descubrimiento de procesos históricos en biología celular.